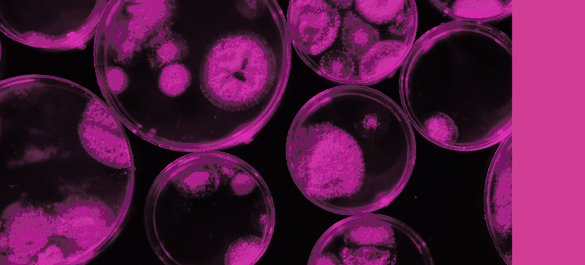
Branding used for Access Microbiology

Editorial Boards
There are six Editorial Boards that represent the Microbiology Society's journals:
- Microbiology Editorial Board
- Journal of General Virology Editorial Board
- Journal of Medical Microbiology Editorial Board
- Microbial Genomics Editorial Board
- International Journal of Systematic and Evolutionary Microbiology Editorial Board
- Access Microbiology Editorial Board
Find out more about each of the Editorial Boards and its members below: